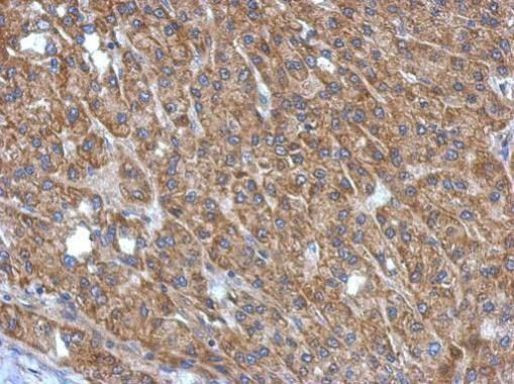
MAPKAP1 Antibody in Immunohistochemistry (Paraffin) (IHC (P))

Search
Invitrogen
MAPKAP1 Polyclonal Antibody
{{$productOrderCtrl.translations['antibody.pdp.commerceCard.promotion.promotions']}}
{{$productOrderCtrl.translations['antibody.pdp.commerceCard.promotion.viewpromo']}}
{{$productOrderCtrl.translations['antibody.pdp.commerceCard.promotion.promocode']}}: {{promo.promoCode}} {{promo.promoTitle}} {{promo.promoDescription}}. {{$productOrderCtrl.translations['antibody.pdp.commerceCard.promotion.learnmore']}}
产品信息
PA5-29178
宿主/亚型
分类
类型
抗原
偶联物
形式
浓度
规格
保存条件
运输条件
RRID
产品详细信息
PA5-29178 targets SIN1 in IHC (P) and WB applications and shows reactivity with Human samples.
The PA5-29178 immunogen is recombinant protein fragment corresponding to a region within amino acids 180 and 442 of Human SIN1.
靶标信息
Sin1 was initially identified as the human homolog of S. pombe SIN1. Recent evidence has shown that it identical to Mip1, a protein that interacts with MEKK2, a member of the mitogen-activated protein kinase (MAPK) intracellular signaling network. MAPKAP1 is thought to prevent MEKK2 activation and dimerization by forming a complex with the inactive and non-phosphorylated MEKK2, thereby blocking the JNK1/2, ERK1/2, p38 and ERK5 MAPKs. MAPKAP1 has also been shown to play a role in the TOR signaling process, a pathway that is involved in controlling cell growth and proliferation in response to environmental cues such as nutrients, growth factors and hormones. Experiments showed that MAPKAP1 helped to maintain the TOR/rictor assembly but not the TOR/RAPTOR complex, which allowed specific phosphorylation of Akt, a kinase that is believed to couple the growth factor-PI3K signaling pathway to the nutrient-regulated TOR signaling pathway. Multiple alternatively spliced isoforms of MAPKAP1 have been identified.
⚠WARNING: This product can expose you to chemicals including mercury, which is known to the State of California to cause birth defects or other reproductive harm. For more information go to www.P65Warnings.ca.gov.
仅用于科研。不用于诊断过程。未经明确授权不得转售。